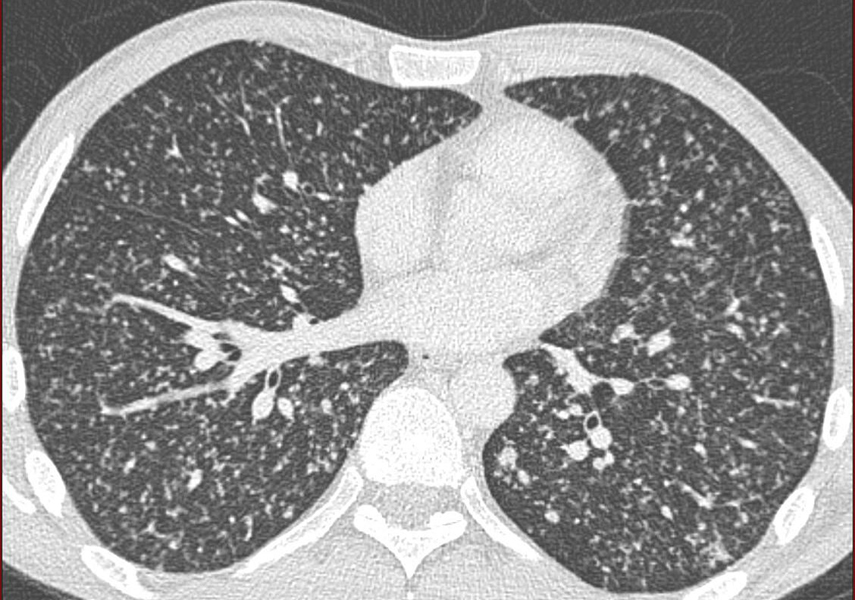
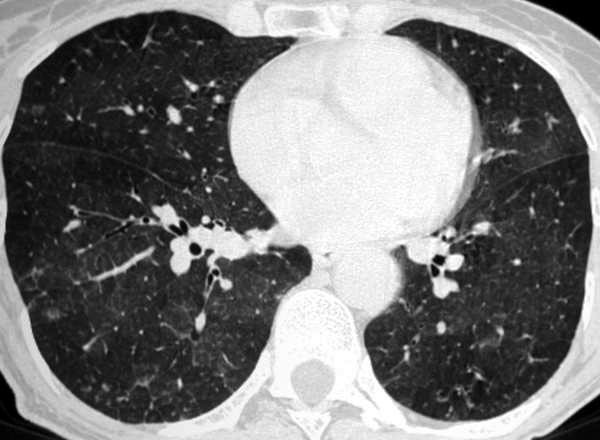

Antécédent cancer du sein en rémission. Syndrome? diagnostic?
Syndrome rétoculo-nodulaire => lymphangite carcinomateuse
Eleveur d’oiseau. lésion élémentaire? Diagnostic?
Nodules de contours flous. pneumopathie d’hypersensibilité
AEG, fièvre, parfois sueurs nocturnes. Patient vivant dans un squat.

Milaire tuberculeuse